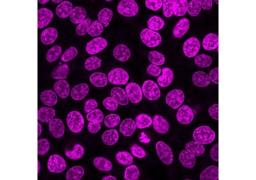

Products & ReviewLife Sciences
NucSpot® Live Cell Nuclear Stains
BiotiumWorldwide
No-wash, fluorescent DNA nuclear stains dyes with low toxicity for long-term live cell imaging or fixed cell staining. Choose green or far-red fluorescence.
NucSpot® Live Cell Nuclear Stains are cell membrane-permeant DNA dyes that specifically stain nuclei in live or fixed cells. They have excellent specificity for DNA without the need for a wash step, with low toxicity for live cell imaging.
Features
- No-wash, nuclear-specific DNA dyes
- Low-toxicity for real-time live cell imaging
- Fix before or after labeling
- NucSpot® Live 650 compatible with SIM, STED, or STORM
- Choose green or far-red fluorescence
NucSpot® Live 488 Nuclear Stain #40081
NucSpot® Live 488 Nuclear Stain, Trial Size #40081-T
NucSpot® Live 650 Nuclear Stain #40082
NucSpot® Live 650 Nuclear Stain, Trial Size #40082-T